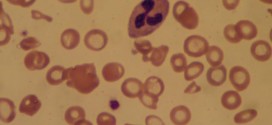

El pioderma gangrenoso (PG). Es una enfermedad caracterizada por la aparición de lesiones en forma de pústulas o nódulos inflamatorios que evolucionan hacia la formación de una ulcera cutánea. Frecuentemente se asocia a patología sistémica. Los mecanismos exactos que conducen a la aparición del PG no se conocen, a saber. Como siempre se nos olvida a todos los motivos de …
Leer MásEnfermedades
OSTEOPOROSIS
La osteoporosis. Formación de espacios anormales en el hueso o su rarefacción sin descalcificación, por ampliación de sus conductos. Reducción de la densidad de los huesos hasta un nivel en que hay afectación de la función de soporte mecánico. Las vértebras, las caderas, las muñecas, el húmero, la tibia son particularmente propensos a las fracturas. Otros nombres o patologías o …
Leer MásNEOPLASIAS GÁSTRICAS
Las neoplasias gástricas. Tumor maligno en general y especialmente el formado por células epiteliales. Los cánceres se dividen en dos grandes categorías de carcinoma y sarcoma, a saber. La característica básica de la malignidad es una anormalidad de las células, a saber, transmitidas a las células hijas, a saber, que se manifiestan por la reducción del control del crecimiento y …
Leer MásMELANOMA DE RIÑON
El melanoma de riñon. Tumor maligno en general y especialmente el formado por células epiteliales, se presenta en el parénquima del riñón, es la forma más usual de cáncer y se origina en la proliferación de células epiteliales de los túbulos renales. Durante los primeros años de vida de una persona, las células normales se dividen más rápidamente para permitir …
Leer MásLIQUEN PLANO
El liquen plano (LP). Es una dermatosis pápulo-escamosa caracterizada en su forma típica por la aparición de pápulas pruriginosas de pequeño tamaño y coloración violácea localizadas preferentemente en superficies flexoras durante la edad media de la vida. Las lesiones cutáneas pueden estar acompañadas por lesiones papulosas de coloración blanquecina en mucosa oral o genital. El curso de la enfermedad suele …
Leer MásHIRSUTISMO
El hirsutismo. El hirsutismo es el crecimiento excesivo de pelo terminal oscuro y denso en mujeres, normalmente en áreas andrógeno-dependientes. La causa es el aumento de producción de andrógenos o el aumento de la sensibilidad de los folículos pilosos a los andrógenos. Existen tres formas de presentarse este trastorno: por alteración funcional, por neoplasias, o inducido por medicamentos (fármacos). Causas: …
Leer MásESFEROCITOSIS HEREDITARIA
La esferocitosis o anemia hemolítica hereditaria o esferocitosis. Forma de anemia hemolítica caracterizada por la presencia de eritrocitos esféricos, poco resistentes y fácilmente hemolizables. En este caso aparece una destrucción de los glóbulos rojos o su disolución debido a un factor agresivo en el plasma (parásito, tóxico o microbio); el enfermo se le ve pálido, con ictericia y hipertrofia del …
Leer MásENFERMEDAD PULMONAR CRÓNICA
La enfermedad pulmonar crónica. Es una enfermedad que se considera permanente (crónica), a saber. Tiene un proceso de obstrucción crónica del flujo espiratorio debida a un enfisema, a menudo por la inflamación de las vías aéreas y broncospasmos, por tabaquismo, vapores tóxicos, contaminación atmosférica, polvos tóxicos de las grandes ciudades, gases tóxicos, etc. Ante todo si fuma hay que dejarlo …
Leer MásDERMATITIS, DERMITIS Y DERMATOSIS
La dermatitis, dermitis y dermatosis. Inflamación de la piel. También tiene otros nombres o enfermedades directas e indirectas pero sien do lo mismo con otros nombre como: dermatitis artefacta, dermatitis de contacto, dermatitis atópica, dermatitis dishidrótica, dermatitis de pañal, dermatitis herpetiforme, o enfermedad de duhring-brocq, dermatitis seborreica, dermatitis de berloque, dermatitis calórica, dermatitis esquistosómica, dermatitis facticia, dermatitis hiemalis, dermatitis papilaris …
Leer MásCONDILOMA ACUMINADO
El condiloma acuminado. Condiloma de aspecto verrugoso y color amarillo, rosado o rojiza generalmente húmeda y que puede adoptar gran tamaño. Los condilomas son ocasionados por el virus de papiloma humano (VPH). Los virus del papiloma ocasionan pequeños crecimientos (verrugas) sobre la piel y membranas mucosas. La infección de las regiones anales y genitales con VPH puede ocasionar verrugas (condiloma …
Leer MásCÁNCER DE PRÓSTATA METASTÁSICO
El cáncer de próstata metastásico. Tumor maligno en general y especialmente el formado por células epiteliales. Publicado en: binipatia.com Sábado, 09 de marzo de 2019 a las 9:10 a.m. Escrito por: Salvador Gregori y Josh Bush Etiquetas: promover la salud verdadera, alimentos seleccionados Resumiendo: La próstata es una glándula que pertenece al sistema reproductor masculino localizada justo por debajo de la vejiga …
Leer MásCÁNCER DE MATRIZ
El cáncer de matriz. Los virus del papiloma humano (VPH) de los tipos 16 y 18 son los principales tipos que se asocian al cáncer ginecológico y genital. A saber, sin olvidar a los demás. Es una forma de cáncer en la cual se encuentran células cancerosas en los tejidos del cuello uterino y el útero. El cuello uterino es …
Leer MásCÁNCER DE ESTÓMAGO
El cáncer de estómago. Tumor maligno en general y especialmente el formado por células epiteliales. El cáncer del estómago es una enfermedad por la que se forman células malignas (cancerosas) en el revestimiento del estómago. El estómago es un órgano en forma de J en la sección superior del abdomen. Forma parte del aparato digestivo, que procesa los nutrientes (vitaminas, …
Leer MásCÁNCER DE ESÓFAGO DISTAL
El cáncer de esófago distal. Tumor maligno en general y especialmente formado por células epiteliales. El esófago es un tubo muscular, hueco, que se extiende desde la faringe hasta el estómago, y sirve para el paso de alimento. En su recorrido, atravesando el cuello y el tórax para llegar al abdomen, se encuentra por delante de la columna vertebral, en …
Leer MásCÁNCER DE HIGADO
El cáncer de hígado. Tumor maligno en general y especialmente el formado por células epiteliales, a saber. El hígado es un órgano grande situado en el lado derecho del abdomen y está protegido por la caja del tórax. El hígado tiene muchas funciones. Juega un papel fundamental en la conversión de los alimentos en energía. También filtra y almacena la …
Leer MásCÁNCER GINECOLÓGICO
El cáncer ginecológico. Los virus del papiloma humano (VPH) de los tipos 16 y 18 son los principales tipos que se asocian al cáncer ginecológico y genital. A saber, sin olvidar a los demás. Los cánceres ginecológicos son cualquier tipo de cáncer que se origina en los órganos reproductores de las mujeres. Algunos cánceres ginecológicos son causados por el virus …
Leer MásCÁNCER DE PULMÓN
Cáncer de pulmón. Otros tipos u nombres: neoplasia pulmonar, neoplasias pleurales primarias, tumores hiliares, tumores en lóbulo medio o lóbulo inferior derecho, neoplasia microcítico pulmonar, neoplasia pulmonar central, neoplasias torácicas, etc. Los pulmones son un par de órganos que dan oxígeno al cuerpo y expulsan el dióxido de carbono, un producto de desecho producido por las células del cuerpo. Los …
Leer MásCÁNCER DE LOS HUESOS
El cáncer de los huesos. Tumor de células plasmáticas, localizado fuera de la médula ósea, caracterizado por la presencia de lesiones óseas diseminadas, paraproteína (inmunoglobulina producida por un clon de células plasmocitarias de proliferación patológica) en la sangre y orina, anemia, trombocitopenia (disminución del número de plaquetas en la sangre (trombopenia) y leucopenia (reducción del número de leucocitos (glóbulos blancos …
Leer MásCÁNCER DE COLÓN Y RECTO
El cáncer de colón y recto, también tiene otros nombres o relacionados como: cáncer colorrectal, cáncer de intestino, carcinoma de colon, metaplasia intestinal, cáncer hereditario de colon, adenocarcinoma colorrectal, carcinoma hereditario de colon no asociado a poliposis, cáncer de colon esporádicos, tumores de ciego, tumores de colon ascendente, tumor del recto distal, tumores carcinoides de apéndice, tumores carcinoides extraintestinales, síndrome …
Leer MásRETICULOSARCOMA
El reticulosarcoma. Tumor linfoide maligno con estructura bastante variada. Las células tumorales pueden ser redondeadas y algo pleomórficas y pueden presentar contornos citoplásmicos bien definidos; algunos de sus núcleos presentan escotaduras o formas de herradura y tienen nucléolos grandes. E n algunos de los casos se pueden observa numerosas fibras de reticulina que pueden estar distribuidas uniformemente entre las células …
Leer Más Binipatia e higienismo Medicina natural alternativa, plantas medicinales y remedios caseros naturales
Binipatia e higienismo Medicina natural alternativa, plantas medicinales y remedios caseros naturales